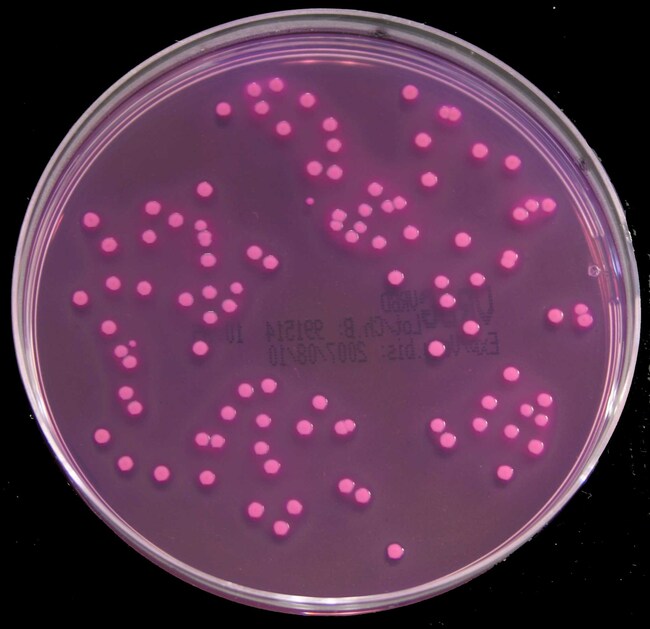
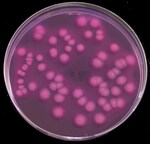
Violet Red Bile Glucose (VRBG) Agar (ISO) (Dehydrated)

Search
Thermo Scientific™
Violet Red Bile Glucose (VRBG) Agar (ISO) (Dehydrated)
Detect and enumerate Enterobacteriaceae in food, animal feed, and environmental samples with this selective medium.
| Catalog Number | Quantity |
|---|---|
| CM1082R | 2.5 kg |
| CM1082B | 500 g |
| CM1082T | 5 kg |
Catalog number CM1082R
Price (CNY)
-
Quantity:
2.5 kg
Selectively enumerate Enterobacteriaceae in food, animal feed, and environmental samples with Thermo Scientific™ Oxoid™ Violet Red Bile Glucose (VRBG) Agar (ISO) tested for performance based on ISO 21528 and ISO 11133:2014. Due to the careful addition of selective inhibitory components, neutral red, crystal violet, and bile salts, the medium provides selectivity against non-target Gram-positive bacteria.
Use Violet Red Bile Glucose (VRBG) Agar for examination of food, animal feed, and environmental samples, for the presence of indicator groups such as coliforms. As well as providing evidence of food hygiene and safety, indicator groups provide a measure of food quality and spoilage potential. One of the most common groups of bacteria employed as indicator organisms by the food industry are the coliforms, which can be regarded as a subgroup within the Enterobacteriaceae. However, in an attempt to improve assessment of food safety and quality by the food industry, there has been a move towards testing for total Enterobacteriaceae rather than limiting testing to coliforms.
In processed foods, particularly foods subjected to heat treatment, these organisms can provide a reliable indication of process failure, under-processing, or post-processing contamination.
Enterobacteriaceae rapidly ferment glucose and so reduce the pH of the medium, which produces purple/pink coloured colonies due to the inclusion of the neutral red indicator and crystal violet in the medium. These colonies are usually surrounded by purple halos of precipitated bile salts. Crystal violet and bile salts inhibit the growth of Gram-positive flora.
Not all products are available for sale in all territories. Please inquire.
Remel™ and Oxoid™ products are now part of the Thermo Scientific™ brand.
In processed foods, particularly foods subjected to heat treatment, these organisms can provide a reliable indication of process failure, under-processing, or post-processing contamination.
- Easy-to-read results: due to inclusion of neutral red indicator and crystal violet in the medium Enterobacteriaceae form purple pink colored colonies.
- Tested for performance based on ISO 21528 and ISO 11133:2014 standards.
Enterobacteriaceae rapidly ferment glucose and so reduce the pH of the medium, which produces purple/pink coloured colonies due to the inclusion of the neutral red indicator and crystal violet in the medium. These colonies are usually surrounded by purple halos of precipitated bile salts. Crystal violet and bile salts inhibit the growth of Gram-positive flora.
Not all products are available for sale in all territories. Please inquire.
Remel™ and Oxoid™ products are now part of the Thermo Scientific™ brand.
General References:
- ISO 11133:2014 Microbiology of food, animal feed and water - Preparation, production, storage and performance testing of culture media.
- Mossel, Eelderink, Koopmans and van Rossem. 1978. Lab Practice 27:1049.
- Mossel, Eelderink, Koopmans and van Rossem. 1979. J. Food Protect. 42:470.
Specifications
DescriptionViolet Red Bile Glucose (VRBG) Agar (ISO) (Dehydrated)
Quantity2.5 kg
Shelf Life5 Years
FormPowder
Product TypeAgar
Unit SizeEach
Contents & Storage
10°C to 30°C